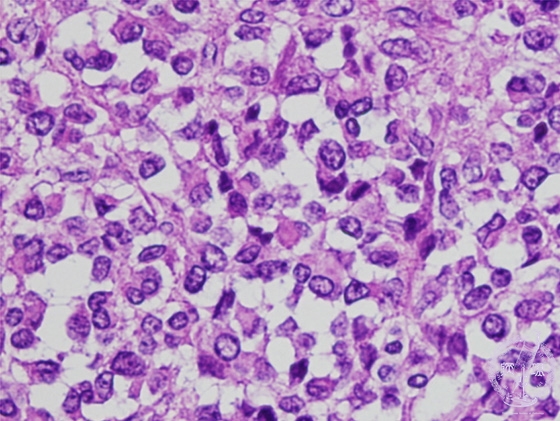

- 18.Soft tissue
- (6)Rhabdomyosarcoma
Microscopic findings (H.E. high power view): Markedly atypical undifferentiated tumor cells with round-shaped rhabdomyoblastic cells harbouring eccentric nuclei and abundant eosinophilic cytoplasms (red circles).
Click the image to see the enlarged image.